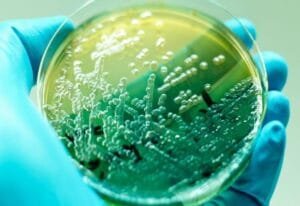

Notícias
ALERTA EPIDEMOLÓGICO: Surtos intra-hospilares de histoplasmose no Brasil
Faça download aqui!

Faça download aqui!

21/11/2025: a Anvisa publica a NOTA TÉCNICA GVIMS/GGTES/DIRE3/ANVISA nº 11 / 2025 Orientações para implementação

A Nota Técnica Conjunta nº 309/2025, elaborada pelo Ministério da Saúde e Anvisa, alerta para

Faça o download aqui!